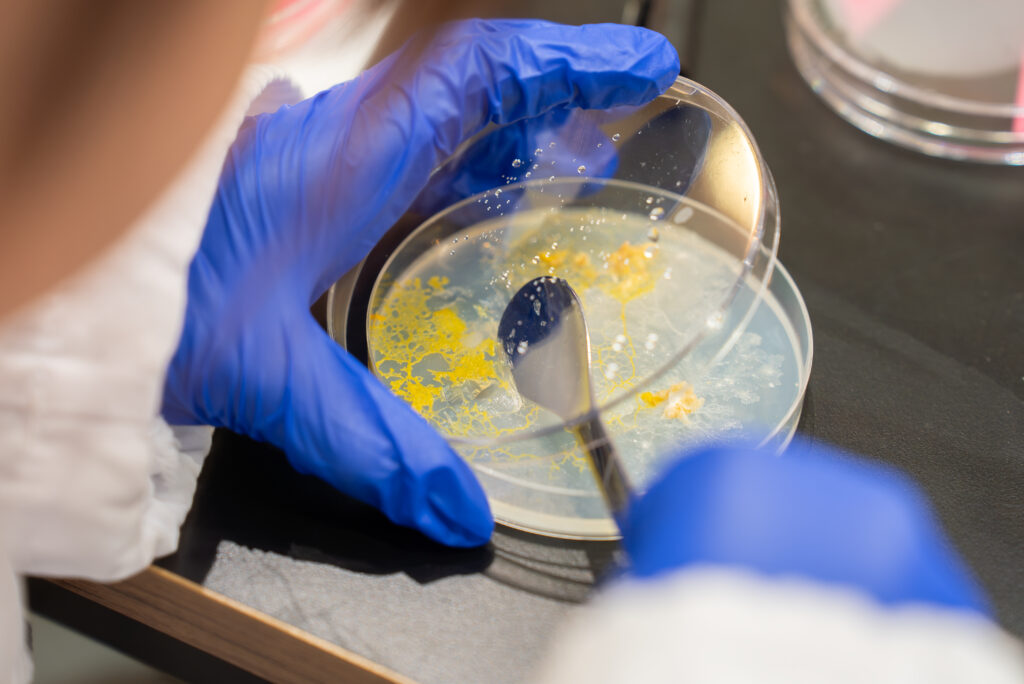
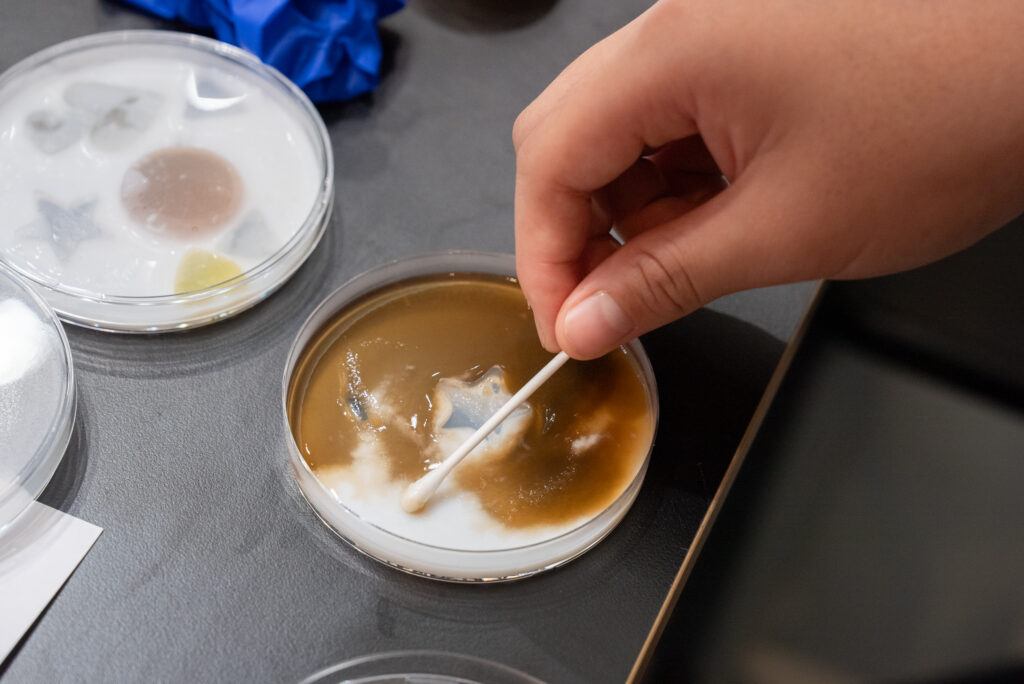

CCBTでアート&テクノロジーに出会う。
一緒につくって学んで、ものづくりの「ひらめき」を見つける。
「ひらめく☆道場」は、アート&テクノロジーとの出会いを通じて、ものづくりの方法や楽しさを発見するきっかけを提供する、様々な分野のクリエイターとCCBTのスタッフが開発したオリジナルのワークショップシリーズです。CCBTの設備「テックラボ」にあるファブリケーション機器を活用した電子工作をはじめ、プログラミングやデザイン、映像、音響などのデジタルクリエイティブの基本を学ぶことができます。2023年7月の開講以来、毎月異なるテーマで開催しており、2025年3月までに全10テーマのワークショップが開発・実施されました。
3つのポイント
- クリエイターと一緒に表現する
「ひらめく☆道場」では、アーティストやエンジニアなど、多彩なクリエイターがカリキュラムをデザインし、講師を務めます。参加者はCCBTで彼らと出会い、実験を通じてともに表現を創り上げることで、アートとデザイン、テクノロジーを使ったものづくりの楽しさを体験します。 - アイデアを実現する力を育む
「ひらめく☆道場」のカリキュラムでは、独創性を重視しており、各自のアイデアを実装できるよう講師が参加者をサポートします。自分だけの表現をイメージしながら手を動かすプロセスを通して、創造性を刺激し、アイデアを実現する力を育みます。 - CCBTでひらめきを拡張する
「ひらめく☆道場」では、ショーケースやアート・インキュベーションなど、CCBTのほかのプログラムに関連したテーマを取り扱います。「ひらめく☆道場」で基礎を学んだ後も、新たな表現や実験を探求できる仕組みを提供することで、「ひらめき」の先にある、さらなる創造に出会える場を生み出しています。
開講テーマ一覧
デジタルファブリケーション入門
レーザーカッター編:アクリルスタンドをつくろう!
アルゴリズムデザインの基礎と、レーザーカッターの活用方法を学ぶ講座。CCBTのロゴに採用されている、シンプルな図形の組み合わせによってオリジナルの絵柄を作成するシステムを活用し、アクリルスタンドを制作します。
デジタルファブリケーション入門
3Dプリンター編 ミニミニコンベアをつくろう!
3Dプリンターの特性と、活用方法を学ぶ講座。デジタルファブリケーション機器を使ってつくられたオリジナルのパーツを組み立て、実際に可動する小さなベルトコンベアをつくります。さらに、つくったベルトコンベアで何が運べるのか、どんな表現ができるのかを考えます。
電子工作入門
モーターを使ってうごきをつくろう!
電子部品と基板、モーターの構造と電子工作の基礎を学ぶ講座。速度や回転方法を変化させ、動きを制御することを通じて、自身のアイデアを実装する方法としての「電子工作」に挑戦します。
夏のエンジニアリング大特訓
動きを観察して、つくってみよう!
動きをつくるための機械的な構造や、モーターの速度や回転のパターンを制御するためのプログラミングを学び、個性的な動きの表現に挑戦する講座。技術の得意な点、不得意な点を考えながら、適切な技術を採用していくことを体験します。
道場の先生:中路景暁(CCBTテクニカルスタッフ/アーティスト、エンジニア)、三浦大輝(CCBTテクニカルスタッフ/エンジニア)
映像制作入門
組み合わせで映像の印象を変えよう!
4Kデジタルビデオカメラと映像編集ソフトを使った表現に取り組む講座。オリジナル作品の制作を通じて、基礎的なテクニックのみならず、映像に隠された技法や効果を発見し、映像表現の可能性を探求します。
道場の先生:乙戸将司(CCBTテクニカルスタッフ)
サウンドデザイン入門
マイクとスピーカーで音の世界を探検しよう!
音の原理や特性とともに、マイクやスピーカーによる表現方法を学ぶ講座。はじめに、オリジナルのシステムを使って、音を発見し、採集することを通して、音をよく聴くことを体験します。次に、音を使った視覚的な表現にも挑戦。複数のアクティビティを通じて音の伝達の仕組みを理解し、音が響くことについて探求します。
プログラミング入門
アルゴリズムで絵を描こう!
既存のアルゴリズム(手順)を活用したプログラミングを学ぶ講座。繰り返しやランダムといった、コンピューターが得意な計算方法を使って、さまざまな模様やグラフィックを描画します。
プログラミング入門
生成AIと一緒にアニメーションをつくろう!
生成AIを使って表現を生み出す方法を学ぶ講座。大量のデータや情報を学習し新しいデータを作り出す技術である生成AIの得意・不得意を理解し、プログラミングを通じてパソコン上で動くアニメーションを描画します。
道場の先生:倉橋真也(エンジニア、アーティスト)
バイオテクノロジー入門
顕微鏡と粘菌でミクロな世界を観察しよう!
紙製の顕微鏡と粘菌を使った実験と観察を通じて、「バイオテクノロジー」の基礎を学ぶ講座。動物でも植物でもない生物「粘菌」にエサと障害物を与え、成長と動きを観察し、生物がもつユニークな機能を発見します。
道場の先生:ゲオアグ・トレメル(アーティスト/BCL、 BioClub Tokyo)
バイオテクノロジー入門
培地をつくってミクロな生物の世界に触れよう!
微生物にとってどんな環境が育ちやすいのか、仮説を立てながら、オリジナルの寒天培地を作り、身の回りの微生物の存在について学ぶ講座。自分の手や、CCBTの床など気になる場所の微生物を培地に採取して、観察します。
道場の先生:羽田光佐(アーティスト)